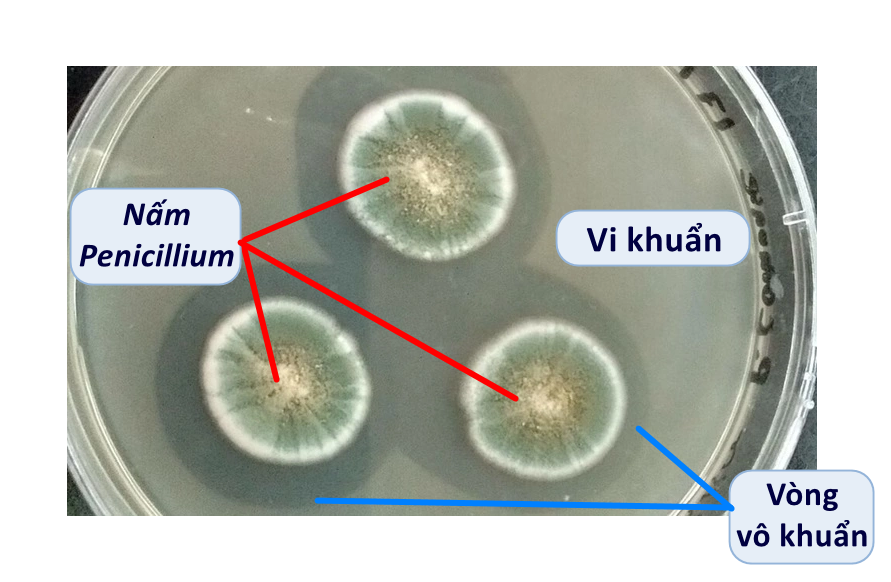

Quan hệ giữa nấm Penicillium với vi khuẩn thuộc quan
Quan hệ giữa nấm Penicillium với vi khuẩn thuộc quan hệ
Đáp án đúng là: C
Quảng cáo
Vận dụng kiến thức đã học về các mối quan hệ trong quần xã sinh vật.
Đáp án cần chọn là: C
>> 2K9 Chú ý! Lộ Trình Sun 2027 - 1 lộ trình ôn đa kỳ thi (TN THPT, ĐGNL (Hà Nội/ Hồ Chí Minh), ĐGNL Sư Phạm, ĐGTD, ĐGNL Bộ Công an, ĐGNL Bộ Quốc phòngTD - Click xem ngay) tại Tuyensinh247.com. Cập nhật bám sát bộ SGK mới, Thầy Cô giáo giỏi, 3 bước chi tiết: Nền tảng lớp 12; Luyện thi chuyên sâu; Luyện đề đủ dạng đáp ứng mọi kì thi.
![]() |
![]() |
![]() |
![]() |
![]() |
![]() |
![]() |
![]() |
Hỗ trợ - Hướng dẫn
-
024.7300.7989
-
1800.6947
(Thời gian hỗ trợ từ 7h đến 22h)
Email: lienhe@tuyensinh247.com












